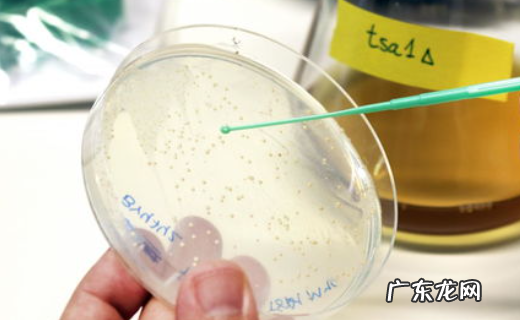

危化品分类危化品分类如下:
第1类爆炸品:本类化学品指在外界作用下(如受热、受压、撞击等),能发生剧烈的化学反应,瞬时产生大量的气体和热量,使周围压力急骤上升,发生爆炸,对周围环境造成破坏的物品,也包括无整体爆炸危险,但具有燃烧、抛射及较小爆炸危险的物品 。

文章插图
第2类压缩气体和液化气体:本类化学品系指压缩、液化或加压溶解的气体,并应符合下述两种情况之一者:a.临界温度低于50℃,或在50℃时 , 其蒸气压力大于294kPa的压缩或液化气体;
b.温度在21.1℃时,气体的绝对压力大于275kPa,或在54.4℃时,气体的绝对压力大于715kPa的压缩气体;或在37.8℃时,雷德蒸气压力大于275kPa的液化气体或加压溶解的气体 。
第3类易燃固体、自燃物品和遇湿易燃物品:易燃固体系指燃点低, 对热、撞击、摩擦敏感, 易被外部火源点燃, 燃烧迅速,并可能散发出有毒烟雾或有毒气体的固体, 但不包括已列入爆炸品的物品 。
自燃物品系指自燃点低, 在空气中易发生氧化反应, 放出热量, 而自行燃烧的物品 。遇湿易燃物品系指遇水或受潮时, 发生剧烈化学反应, 放出大量的易燃气体和热量的物品 。有的不需明火 , 即能燃烧或爆炸 。
第4类氧化剂和有机过氧化物:氧化剂系指处于高氧化态, 具有强氧化性,易分解并放出氧和热量的物质 。包括含有过氧基的无机物, 其本身不一定可燃, 但能导致可燃物的燃烧,与松软的粉末状可燃物能组成爆炸性混合物,对热、震动或摩擦较敏感 。
有机过氧化物系指分子组成中含有过氧基的有机物, 其本身易燃易爆,极易分解 , 对热、震动或摩擦极为敏感 。

文章插图
第5类有毒品:本类化学品系指进入肌体后, 累积达一定的量, 能与体液和器官组织发生生物化学作用或生物物理学作用,扰乱或破坏肌体的正常生理功能, 引起某些器官和系统暂时性或持久性的病理改变, 甚至危及生命的物品 。
经口摄取半数致死量:固体LD50≤500mg/kg; 液体LD50≤2000mg/kg; 经皮肤接触24h, 半数致死量LD50 ≤1000mg/kg; 粉尘、烟雾及蒸气吸入半数致死量LC50≤10mg/L的固体或液体 。
第6类腐蚀品:本类化学品系指能灼伤人体组织并对金属等物品造成损坏的固体或液体 。与皮肤接触在4h内出现可见坏死现象,或温度在55℃时,对20号钢的表面均匀年腐蚀率超过 6.25mm/年的固体或液体 。
危化品危险性分级法律分析:第一类,爆炸品;第二类,压缩气体和液化气体;第三类,易燃液体;第四类,易燃固体、自燃物品和遇湿易燃物品;第五类,氧化剂和有机过氧化物;第六类,毒害品和感染性物品;第七类,放射性物品;第八类,腐蚀品.
法律依据:《化学品物理危险性鉴定与分类管理办法》 第三条 本办法所称化学品,是指各类单质、化合物及其混合物 。化学品物理危险性鉴定,是指依据有关国家标准或者行业标准进行测试、判定,确定化学品的燃烧、爆炸、腐蚀、助燃、自反应和遇水反应等危险特性 。化学品物理危险性分类,是指依据有关国家标准或者行业标准,对化学品物理危险性鉴定结果或者相关数据资料进行评估,确定化学品的物理危险性类别 。
危化品分类都有哪些化学品按其危险性分为八大类:
第一类:爆炸品,是指在外界作用下(如受热、摩擦、撞击等)能发生剧烈的化学反应,瞬间产生大量的气体和热量 , 使周围的压力急剧上升,发生爆炸,对周围环境、设备、人员造成破坏和伤害的物品 。

文章插图
第二类:压缩气体和液化气体,指压缩的、液化的或加压溶解的气体 。

文章插图
第三类:易燃液体,本类物质在常温下易挥发,其蒸气与空气混合能形成爆炸性混合物 。

文章插图
第四类:易燃固体、自燃物品和遇湿易燃物品,这类物品易于引起火灾 。

文章插图
第五类:氧化剂和有机过氧化物 , 这类物品具有强氧化性,易引起燃烧、爆炸 。
文章插图
第六类:毒害品,指进入人(动物)肌体后,累积达到一定的量能与体液和组织发生生物化学作用或生物物理作用 , 扰乱或破坏肌体的正常生理功能,引起暂时或持久性的病理改变 , 甚至危及生命的物品 。

文章插图
第七类:放射性物品,它属于危险化学品,但不属于《危险化学品安全管理条例》的管理范围,国家还另外有专门的“条例”来管理 。

文章插图
第八类:腐蚀品,指能灼伤人体组织并对金属等物品造成损伤的固体或液体 。

文章插图
根据《危险化学品安全管理条例》第三条
本条例所称危险化学品 , 是指具有毒害、腐蚀、爆炸、燃烧、助燃等性质,对人体、设施、环境具有危害的剧毒化学品和其他化学品 。
危险化学品目录,由国务院安全生产监督管理部门会同国务院工业和信息化、公安、环境保护、卫生、质量监督检验检疫、交通运输、铁路、民用航空、农业主管部门,根据化学品危险特性的鉴别和分类标准确定、公布,并适时调整 。
第五条任何单位和个人不得生产、经营、使用国家禁止生产、经营、使用的危险化学品 。国家对危险化学品的使用有限制性规定的,任何单位和个人不得违反限制性规定使用危险化学品 。
以上内容参考
危险品分类9大类各是哪些法律分析:
根据我国危险化学品安全管理条例的规定,9类危险品主要包括:第一类:爆炸品;第二类:压缩气体;第三类:易燃液体;第四类:易燃固体;第五类:氧化物有机过氧化物;第六类:有毒物质;第七类:放射性物质;第八类:腐蚀品;第九类:杂项 。爆炸物、压缩气体、易燃液体、易燃固体、氧化物、有毒物质、放射性物质、腐蚀性物质和电池 。危险品是易燃、易爆、强腐蚀、有毒、放射性物质的总称 。如汽油、炸药、强酸、强碱、苯、萘、赛璐珞、过氧化氢等 。运输和储存应符合危险品规定 。载运危险品的车辆不得停放在人口稠密、集镇、交通要道、居民区等房东内,载运危险品的车辆不得停放在自己的车间、院子内 。装卸不及、停放或通宵修理时 , 应向领导或值班人员报告 , 并采取必要的防护措施 。托运人托运易燃、易爆、有毒、有腐蚀性、有放射性等危险物品的,应当按照国家有关危险物品运输的规定对危险物品妥善包装,做出危险物品标志和标签,并将有关危险物品的名称、性质和防范措施的书面材料提交承运人 。托运人违反前款规定的 , 承运人可以拒绝运输,也可以采取相应措施以避免损失的发生,因此产生的费用由托运人负担 。
法律依据:《危险化学品安全管理条例》 第三条 本条例所称危险化学品,是指具有毒害、腐蚀、爆炸、燃烧、助燃等性质 , 对人体、设施、环境具有危害的剧毒化学品和其他化学品 。危险化学品目录,由国务院安全生产监督管理部门会同国务院工业和信息化、公安、环境保护、卫生、质量监督检验检疫、交通运输、铁路、民用航空、农业主管部门 , 根据化学品危险特性的鉴别和分类标准确定、公布,并适时调整 。
【危化品三类包括什么,危化品分类都有哪些】
- 茶艺主题名字,品饮茶艺赛项目前一共有几个主题内容
- 一次性用品有哪些 酒店一次性用品有哪些
- 丙二醇是危险品吗 丙二醇是危险品吗?
- 氧泡泡有哪些坏处,类似氧泡泡的产品
- hydrabio serum是什么,serum 化妆品中的意思
- 真丝绡是什么面料,毛毡设计作品欣赏
- 巴宝莉发源地,华为品牌简介
- 坚果是什么品种的猫 坚果是什么
- 什么物品是蓝色的圆形的,什么东西是蓝的
- 超市里哪些物品用千克作单位,超市千克的东西有哪些物品
特别声明:本站内容均来自网友提供或互联网,仅供参考,请勿用于商业和其他非法用途。如果侵犯了您的权益请与我们联系,我们将在24小时内删除。
